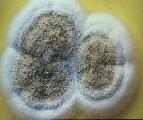

a conversation with Sawaragi Noi and Norimizu Ameya
![]()
AUM AND JAPANESE SUBCULTURE
by Krystian Woznicki

a conversation with Sawaragi Noi and Norimizu Ameya
![]()
AUM AND JAPANESE SUBCULTURE
by Krystian Woznicki
909, Anomally II, a group show (Roentgen Kunst Institut, March/95) curated by Sawaragi Noi features Technocrat, an artist group adressing environmental issues in their work, the hyper pop duo Complesso Plastico, Takashi Nemoto, a manga artist and Yamatsuke Eye, the Boredoms member who contributed wall paintings and 'objects' to this exhibition. On two nights Heino Keiji, Masaya Nakahara (Violent Onsen Geisha) and Yoshihide Otomo performed within the huge gallery space. This show is conceived to discuss the contemporary situation of pop in Japan; 909 being the phenomena Sawaragi views as indicating its parameters. Could you explain briefly that phenomena you call 909?
 Sawaragi Noi: 909 is the mirror reverse image of POP. If pop art
is an American thing, then Japanese pop is a delayed and altered imitation
of it. This delayed version has positive and negative connotations.
The conventional idea is to take something American and improve, upgrade
it. Technically the quality can be improved, but it cannot be surpassed.
The idea of making something better is of course false: you can take
a Fender guitar and decide to make that guitar in Japan, but it won't sound
better because the environment is different. The process of bringing
something over involves a delay. Japanese are always sensitive about behind
the times.
Sawaragi Noi: 909 is the mirror reverse image of POP. If pop art
is an American thing, then Japanese pop is a delayed and altered imitation
of it. This delayed version has positive and negative connotations.
The conventional idea is to take something American and improve, upgrade
it. Technically the quality can be improved, but it cannot be surpassed.
The idea of making something better is of course false: you can take
a Fender guitar and decide to make that guitar in Japan, but it won't sound
better because the environment is different. The process of bringing
something over involves a delay. Japanese are always sensitive about behind
the times.
However thinking of this lag, - visible in film, music
or fine art- as something distinctive Japanese, you could use it in a
positive way. And that is part of the concept for 909: that gap is not
a delay, but something central to the originality of Japanese pop. And
it is not an originality deriving from Japanese history, but something foreign
that has been processed into its 'own' thing. Take Yamatsuke Eye as
an example. He was confronted with the problem of making rock music
in Japan. To sing in Japanese wouldn't have worked because the rythm
and sounds don't match the language. To sing in English would have
embarassed people. Therefore his words are not in any langugage.
They are screams and shouts. But that screaming is not a positive expression.
It comes from the negative fact that he wasn't able to use either,
Japanese nor English: he had no choice but to shout.The notion of taking
a weak point and turning it into something positive is a fundamental
process for 909.
 Let's look at the choice of artists: all of them are exceptional
within their fields. By combing them in a show one could associate it
with one
of those -best of- productions, in which regardless of genre and
discipline Japan's cultural elite comes together. Take the Geisha
Girls album as a recent example! A project combining the comedian duo
Downtown,
Riyuichi Sakamoto, Towa Tei, Arto Lindsay and the Boredoms.
Let's look at the choice of artists: all of them are exceptional
within their fields. By combing them in a show one could associate it
with one
of those -best of- productions, in which regardless of genre and
discipline Japan's cultural elite comes together. Take the Geisha
Girls album as a recent example! A project combining the comedian duo
Downtown,
Riyuichi Sakamoto, Towa Tei, Arto Lindsay and the Boredoms.
SN: Well you know, sinceWWII a disolution of borderlines between genres set in. There has been an incredible mixture and cross current among the arts. The lesson to be learned from that is that we can bring out the positive nature of this randomness and apply it to an international scale. The breakdown of genres and the destruction of high and low cultures is another concern of the show. Rather than thinking of the artists as working in seperate fields, it is attempted to discover their similarities and to expand on that.
The immediate post war era was distinguished by various controversies.
With the defeat and the occupation forces imposing a so called
democracy upon Japan a second highly paradoxical reopening of Japan set
in. Although a new social value system went into effect, the political
leaders of the wartime goverment went back to running the country.
Especially the issue of digesting the wartime attrocities was
an immense problem and contributed to a distancing from wartime, and thereby
from world history. Japan began to create an enclosed environment but
was at the same time relying on the communication with America. We can
understand this distancing from history as setting the basis for
that empty sapce after WWII . Which effects did this have on Japan's
interiority? 
SN: Rather than thinking of history as a vertical construct you could see it as expanding horizontally over an area that spreads in different directions. That lateral expansion - which these artists are certainly a product of- is based, or rather grounded on that empty space after WWII. You could pick whatever you wanted.
Most of it came from America...
SN:... yeah, even during the 50's and 60's people were more concerned
with that gap between the West and how they were behind, rather
than with
their historical identity. Japanese have always been critisized
for having no sense of history. But in the sixties there were student
demonstrations, where people tried to reaquire history, using
violence for political gains. They failed. When they realized that nothing
had changed a general apathy set in and they decided not to get involved
anymore. In the 70's constant comparisons with America began slowly
to disappear, probably due to economical expansion Then in the eighties
self confidence grew, since Japan entered the "bubble" era.
Still, it didn't have much effect on people's live on a deeper level. At this time
we started to question whether we had an culture on our own.
As it became apparant that there was no "real" Japanese
culture that
vacuum came to its head and even unbearable, since people cannot
live in
this state. There was no escape because Japan was to powerful
at this
moment to regress.
This is when Japan's relations to the States gained a new dimension
and
everything turned upside down.
SN:... yeah, even during the 50's and 60's people were more concerned
with that gap between the West and how they were behind, rather
than with
their historical identity. Japanese have always been critisized
for having no sense of history. But in the sixties there were student
demonstrations, where people tried to reaquire history, using
violence for political gains. They failed. When they realized that nothing
had changed a general apathy set in and they decided not to get involved
anymore. In the 70's constant comparisons with America began slowly
to disappear, probably due to economical expansion Then in the eighties
self confidence grew, since Japan entered the "bubble" era.
Still, it didn't have much effect on people's live on a deeper level. At this time
we started to question whether we had an culture on our own.
As it became apparant that there was no "real" Japanese
culture that
vacuum came to its head and even unbearable, since people cannot
live in
this state. There was no escape because Japan was to powerful
at this
moment to regress.
This is when Japan's relations to the States gained a new dimension
and
everything turned upside down.
SN: At that point people decided not to go on comparing themselves with the West, but to create something that is originally Japanese. However, we had to realize that it wasn't possible to bring out something originally Japanese. It wasn't in us to begin with, since we had been born after WWII and raised in a society, that was completely based on American culture...
Norimizu Ameya: In the mid eighties a Kayokyoku group called Onyanko club gained popularity which seemed to make perfect sense at that time..
SN:..which aslo touches on that aspect of 909...
 NA: Yeah, you could think of it as relating to that subject; that
phenomena of their popularity. But let me talk about how it came
about.
Up to that point pop music was copying Western styles, they were
trying
to sound like Americans. The Onyanku club implied a remarkable
statement:
We are not good and that's OK. Just letting them sing with all
their
might was probably in fact better than producing these powerful
vocalists
who tried to sound blacker than black. The Onyaku club was a direct
response to this inferiority complex towards the West. However,
the
Onyanku Club was something produced and packaged. There was an
innocense
about them. A few years later girls would get in front of people
and say
openly that they were bad at singing and apologize for it: "I'm
bad at
singing but if you want to continue listening to it, then please
do."
Then there was this woman, Moritaka Chisato, who was very popular
especially among Otaku. That was around '88. She had a fanatic
following.
The Onyanku club was not self realized, but Moritaka Chisato came
out on
her own with a debut big hit: "The Anti-Ability Proclamation".
This song
which celebrated a total lack of capability has also a historical
analogy. It reminds me of "The Human Proclamation" which
the Emperor made
after WWII. Before the end of WWII the Japanese Emperor was not
only a
powerful head of state, but also considered a descendent of deities.
He
led the Japanese army through the war. It was only after Japan
was
defeated it did become apparant that our actions had been aggressions.
It
was at this time that he made "The Human Proclamation"
denouncing all
capabilities as Japan's leader. By throwing away his powerpeople
could
say that they were deceived by the Emperor. At this moment the
notion of
"anti-ability" began to apply to culture.
When I first saw Aum Shinrikyo's election cars, with
Japanese
girls on the top of it, singing and dancing I was amazed. No other
political party would do that. It was reminisent of Kayokyoku
and its use
of idols.
NA: Yeah, you could think of it as relating to that subject; that
phenomena of their popularity. But let me talk about how it came
about.
Up to that point pop music was copying Western styles, they were
trying
to sound like Americans. The Onyanku club implied a remarkable
statement:
We are not good and that's OK. Just letting them sing with all
their
might was probably in fact better than producing these powerful
vocalists
who tried to sound blacker than black. The Onyaku club was a direct
response to this inferiority complex towards the West. However,
the
Onyanku Club was something produced and packaged. There was an
innocense
about them. A few years later girls would get in front of people
and say
openly that they were bad at singing and apologize for it: "I'm
bad at
singing but if you want to continue listening to it, then please
do."
Then there was this woman, Moritaka Chisato, who was very popular
especially among Otaku. That was around '88. She had a fanatic
following.
The Onyanku club was not self realized, but Moritaka Chisato came
out on
her own with a debut big hit: "The Anti-Ability Proclamation".
This song
which celebrated a total lack of capability has also a historical
analogy. It reminds me of "The Human Proclamation" which
the Emperor made
after WWII. Before the end of WWII the Japanese Emperor was not
only a
powerful head of state, but also considered a descendent of deities.
He
led the Japanese army through the war. It was only after Japan
was
defeated it did become apparant that our actions had been aggressions.
It
was at this time that he made "The Human Proclamation"
denouncing all
capabilities as Japan's leader. By throwing away his powerpeople
could
say that they were deceived by the Emperor. At this moment the
notion of
"anti-ability" began to apply to culture.
When I first saw Aum Shinrikyo's election cars, with
Japanese
girls on the top of it, singing and dancing I was amazed. No other
political party would do that. It was reminisent of Kayokyoku
and its use
of idols.
THE ECONOMIC MIRACLE, APOCALYPTIC PROPHECIES AND THE UNDIGESTED PAST
Talking about cute/guiltfree girls and Aum Shinrikyo many associate
Asahara Shoko with Charles Manson and his era . He twisted that
notion
of love, peace and freedom around into satan worship. On the surface
level there are some parallels: Just as Manson, Asahara played
the
guitar, both identified with Christ, Armageddon can be seen as
Helter
Skelter, even the use of psychedelic drugs is similar. Still,
crucial
situations are different. As Matsui Midori pointed out in
1994: "The
expenditure practised in the States during the sixties far exceeds
the
scale of consumerism during the eighties, the years of Japanese
'bubble
economy'.

 While in America, especially in the years of its capitalistic
expansion, conspicious consumption was not irrelevant to the national
ideals of the American dream, in Japan, consumption has always
been
accompanied by a sense of guilt. That guilt was not prompted by
a
rational, ethical reflection, but by the nostalgia for the "spirituality"
forgotten in the process of overrapid modernization. That sense
of guilt
, in turn, produced the "myths of spirituality" and
a tendency to
rediscover Japan's ethnological origions, which, unleashed in
the late
60's and 70's , came in the 80's to a climax ." The antiquity
boom of
the 70's was also fired by novelists , particulary Seicho Matsumoto,
a
well-known mystery writer with a passion for Japan's ancient
past with
its many unknowns. Around 1980 , an NHK (Japan Broacasting Corporation)
television series covered massively on the archeological remains
of the
Silk Road and discoveries of major sites in Japan. In the 1980's
Akira
with its apocalyptic future vision appeared and in 1984 Shoko
Asahara
started his activities forming Aum, running a book publishing
firm and
yoga training centers. How did you experience the beginnings
of this
time ?
While in America, especially in the years of its capitalistic
expansion, conspicious consumption was not irrelevant to the national
ideals of the American dream, in Japan, consumption has always
been
accompanied by a sense of guilt. That guilt was not prompted by
a
rational, ethical reflection, but by the nostalgia for the "spirituality"
forgotten in the process of overrapid modernization. That sense
of guilt
, in turn, produced the "myths of spirituality" and
a tendency to
rediscover Japan's ethnological origions, which, unleashed in
the late
60's and 70's , came in the 80's to a climax ." The antiquity
boom of
the 70's was also fired by novelists , particulary Seicho Matsumoto,
a
well-known mystery writer with a passion for Japan's ancient
past with
its many unknowns. Around 1980 , an NHK (Japan Broacasting Corporation)
television series covered massively on the archeological remains
of the
Silk Road and discoveries of major sites in Japan. In the 1980's
Akira
with its apocalyptic future vision appeared and in 1984 Shoko
Asahara
started his activities forming Aum, running a book publishing
firm and
yoga training centers. How did you experience the beginnings
of this
time ?
SN: In the 1970's when I was just at elementary school I read a lot about Nostradamus and his prophecies. There was an obsession at time with psychic phenomena which was massively promoted by mass media. This fascination with Armageddon appeared first with the end of the student demonstrations when a sort of ideological vacuum was felt. People were depolitisized and removed from history. In the 70's even art took a turn towards Zen: the motto was going back to nothingness. Psychic powers and prophecies fit in perfectly in this scenario. A surprising number of people believed that the end of the world would be in 1999.
I see this date also in relation to the Great Kanto Earthquake (1924) that killed 140.000 people, laid to waist two-thirds of Tokyo and flattened neighbouring Yokohama. Relying on historical knowledge -monstrous earthquakes have pummelled Kanto with clockwork regularity, once every 69 years on average- but also due to scientific prognosis Tokyo is expected to be hit by that earthquake before the decade is out,- and the ground shakes here almost everyday. Even looking at the nature and pace of city planning in Tokyo. It is not surprising to acknowledge a missing tangibility concerning ones environment.There is at least a sub concious effect on people.. But also the atomic bomb must have had some consequences, besides negative reminisences towards America.
 SN: Of course, the idea of Armageddon goes also back to Hiroshima.There
has always been a pattern of destruction and reconstruction in
Japanese
history eg. the Meiji Restoration was brought by the arrival of
the
"kurofune" (black ships): whatever we had built so far
has been
destroyed. This notion is omnipresent in people's minds. In the
eighties
the image of Armageddon was popular in Manga etc. It came to
be called
Japanese Cyberpunk which is actually quite different from Cyberpunk
in
the States. It generated out of this vacuum, that we have been
talking
about before, hence it has a different symbolisism.
SN: Of course, the idea of Armageddon goes also back to Hiroshima.There
has always been a pattern of destruction and reconstruction in
Japanese
history eg. the Meiji Restoration was brought by the arrival of
the
"kurofune" (black ships): whatever we had built so far
has been
destroyed. This notion is omnipresent in people's minds. In the
eighties
the image of Armageddon was popular in Manga etc. It came to
be called
Japanese Cyberpunk which is actually quite different from Cyberpunk
in
the States. It generated out of this vacuum, that we have been
talking
about before, hence it has a different symbolisism.
NA: If Cyberpunk is supposed to be a vision of the near future, the Japanese Cyperpunk is more of nostalgic reference to the past. I have always felt that Japanese Cyberpunk is more about the end of WWII.
SN: And there is a need to analyze that. Otherwise it would be superficially passed as another clichee of Japan.
NA: Even talking about Blade Runner, I have to say that for me those are images of the past; and in Tetsuo I saw reflections of the poverty after WWII. Blade Runner reminded me so much of Akihabara and the bombed Dome of Hiroshima. You know, the electronics section of Akihabara used to be barracks at the end of WWII. It was a temporary structure that later became a high-tech image for the West. In the same way Blade Runner wasn't a story about the future for me, but reminisent of the past; bearing something very familiar and sympathetic.
PARASITARY VS. OPPOSING. POTENTIAL AND DANGER
 To return once again to the issue of spirituality, I would like
to point
out the role of Nakazawa Shinichi in this context. A religious
theorist
and postmodern philosopher of the new academist movement in Japan,
Nakazawa enjoys pop star status in this country. In 1990 he made
interviews with Asahara for the popular magazines SPA and Brutus,
spreading a rather ambigious and controversial attitude towards
Asahara's
thinking and vision. Frequent meetings between Asahara and other
Japanese
intellectuals gradually expanded the public perception of the
new cult,
which, at that time, was mainly distinguished by a negative attitude
supported by suspicions of Aum's involvement in the mysterious
disappearance of a lawyer who represented parents of Aum followers.
Nakazawa and Asada Akira had a debate in Shokun(July 95) on Aum
Shinrikyo. Their criticism was focused to dismantle Aum Shinrikyo's
approach as incompatible (and therefore unrealistic and wrong)
with
exsisting standards and structures. Beyond that, and probably
more
important, they repeatedly emphasize the misinterpretation of
a set of
contemporary philosophical thoughts based on Buddhist and Hindu
concepts
eventually encouraging Aum to pursue a '360-degree-change', proving
itself not only as a fruitless point of departure, but as a dangerous
stance. Their critical concern is, to a certain degreee, interlaced
with
personal irritation: more than 80% of Aum followers had read Nakazawa's
works, e.g. the popular bestseller "Mozart in Tibet"
(1984) in which the
Tibetan Buddhist concept of "shuke" (losening ones social
bonds/leaving
society) is of importance. One probably has to see these contradictions
in context with the postmodern debate in Japan which reached in
1984 its
summit. The discomfort felt with postmodern currents in Japan
was not, as
the critic Karatani Kojim points out, "because the observations
of
postmodern theorists did not fit Japan, but because they fit
too
closely. There was a subtle difference in the Japanese situation.
Rather
than maintaining an awareness of the ineluctable nature of modernity,
Japanese postmodernism transcended modernity in a single stroke.
It is
not difficult to reject Japanese modernity, for its history is
very
short." He further expressed his strong misgivings about
"importing" the
"anti-rational" theories of "deconstruction"
and "postmodernism" into a
society in which the lack of structural rationality itself has
constituted the matrix of Japanese totalitarian sentiment and
in which
"structurelessness", in turn, was nurtured by contemporary
mass media.
To return once again to the issue of spirituality, I would like
to point
out the role of Nakazawa Shinichi in this context. A religious
theorist
and postmodern philosopher of the new academist movement in Japan,
Nakazawa enjoys pop star status in this country. In 1990 he made
interviews with Asahara for the popular magazines SPA and Brutus,
spreading a rather ambigious and controversial attitude towards
Asahara's
thinking and vision. Frequent meetings between Asahara and other
Japanese
intellectuals gradually expanded the public perception of the
new cult,
which, at that time, was mainly distinguished by a negative attitude
supported by suspicions of Aum's involvement in the mysterious
disappearance of a lawyer who represented parents of Aum followers.
Nakazawa and Asada Akira had a debate in Shokun(July 95) on Aum
Shinrikyo. Their criticism was focused to dismantle Aum Shinrikyo's
approach as incompatible (and therefore unrealistic and wrong)
with
exsisting standards and structures. Beyond that, and probably
more
important, they repeatedly emphasize the misinterpretation of
a set of
contemporary philosophical thoughts based on Buddhist and Hindu
concepts
eventually encouraging Aum to pursue a '360-degree-change', proving
itself not only as a fruitless point of departure, but as a dangerous
stance. Their critical concern is, to a certain degreee, interlaced
with
personal irritation: more than 80% of Aum followers had read Nakazawa's
works, e.g. the popular bestseller "Mozart in Tibet"
(1984) in which the
Tibetan Buddhist concept of "shuke" (losening ones social
bonds/leaving
society) is of importance. One probably has to see these contradictions
in context with the postmodern debate in Japan which reached in
1984 its
summit. The discomfort felt with postmodern currents in Japan
was not, as
the critic Karatani Kojim points out, "because the observations
of
postmodern theorists did not fit Japan, but because they fit
too
closely. There was a subtle difference in the Japanese situation.
Rather
than maintaining an awareness of the ineluctable nature of modernity,
Japanese postmodernism transcended modernity in a single stroke.
It is
not difficult to reject Japanese modernity, for its history is
very
short." He further expressed his strong misgivings about
"importing" the
"anti-rational" theories of "deconstruction"
and "postmodernism" into a
society in which the lack of structural rationality itself has
constituted the matrix of Japanese totalitarian sentiment and
in which
"structurelessness", in turn, was nurtured by contemporary
mass media.
It was recoginzed by Sawaragi Noi that Japanese art
should
exploit and practise a critique of commodity oriented consummer
culture
from within. A strategy , in harsh contrast to the Japanese avantgarde,
that uses the concept of political opposition. It consequently
takes an
isolated outsider position within Japanese society also bears
a sense of
incommunicability. What the politically active music critic Gen
Hirai
describes in " A Personal and Provisional Report of an Orientation
of
Japanese Art=Politics in the 80's" as the emergence of a
new relational
field between art and politics in the late 70's" represents
only an
exceptional minority. "In the 80's, more than one hundred
musicians,
actors, dramatists, performers, cineasts and so on, started to
connect
themselves with the struggles of daily laborers living in Sanya,
[ a
slum area in Tokyo].." .
SN: I wonder about the "real" political value of their work, or rather its political influence on society. Isn't it rather somekind of protest? What are the consequences? The old fashioned notion of left and right , and politically conscious art being necessarily leftish, is not applicable anymore. For me contemporary political art should analyze the common basis of left and right, which motivates society.
How about Eye?
SN: Yamatsuke Eye is not even to be seen in the conventional context of avantgrade and leftish politics. Eye is not experimental. His ability and know how has been taken and popularized: his work is sellable. Yoshihide Otomo on the contrary, is still using the concept of avantgarde. The political nature lies in the method. And that's why Yamatsuke Eye is more interesting for me than Otomo.
GROUPISM
 In the introduction text of the catalogue for Anomaly I (1993),
Sawaragi
elaborates on the origin of current coordinates for modern art
in Japan,
calling it latteraly written, as opposed to the vertical Japanese
writing
system. He recognizes the present condition of Japan's identity
process
after decades of Internationalism and Orientalism in a state of
refusing
the outside an ideal mirror to reflect its image. "The latterally
written Japanese modern art [...] complies the "modern art"
with
stutters, in the language of "pop" [...] the best model
for [this, is] in
the thinkings of Gilles Deleuze: where he takes literal styles
as
stutters of native language. And this logic of sense is deeply
extending
the senses of the artists here; who have chosen strange names
such as
Kenji Yanobe in katakana, Gabin Ito [Yamatsuke Eye and probably
also
including himself:Sawaragi Noi], sounding too comical to be Japnese
names. There is no doubt that these strange names will spoil the
aesthetics-fostered by the landscape of modernity- of this country
". It
seems that for some people these theories -one cannot deny their
currency- almost function as a religion. But maybe it is a natural
thing
, a matter of different opinions and views, that seperates those
from
others. However, I would like to talk about the issue of groupism
and
cult in contemporary Japanese youth culture. An issue surely not
easy to
discuss after Aum and with somebody, whose work might suffer
misinterpretation and/or undergo legitimate critique. But before
I turn
the conversation back to Norimizu Ameya I would like to mention
some
things before-hand.
In the introduction text of the catalogue for Anomaly I (1993),
Sawaragi
elaborates on the origin of current coordinates for modern art
in Japan,
calling it latteraly written, as opposed to the vertical Japanese
writing
system. He recognizes the present condition of Japan's identity
process
after decades of Internationalism and Orientalism in a state of
refusing
the outside an ideal mirror to reflect its image. "The latterally
written Japanese modern art [...] complies the "modern art"
with
stutters, in the language of "pop" [...] the best model
for [this, is] in
the thinkings of Gilles Deleuze: where he takes literal styles
as
stutters of native language. And this logic of sense is deeply
extending
the senses of the artists here; who have chosen strange names
such as
Kenji Yanobe in katakana, Gabin Ito [Yamatsuke Eye and probably
also
including himself:Sawaragi Noi], sounding too comical to be Japnese
names. There is no doubt that these strange names will spoil the
aesthetics-fostered by the landscape of modernity- of this country
". It
seems that for some people these theories -one cannot deny their
currency- almost function as a religion. But maybe it is a natural
thing
, a matter of different opinions and views, that seperates those
from
others. However, I would like to talk about the issue of groupism
and
cult in contemporary Japanese youth culture. An issue surely not
easy to
discuss after Aum and with somebody, whose work might suffer
misinterpretation and/or undergo legitimate critique. But before
I turn
the conversation back to Norimizu Ameya I would like to mention
some
things before-hand.
The formation of cult like groups around one star came
to its
climax also during the eighties. Pop stars on the one hand are
not
rarely distinguished by a pool of loyal fans, who as in the case
of Okada
Yukiko follow their idol even into death. (The idol singer Okada
Yukiko
died in 1987, which triggered some 50 youths suicide). Musicians,
such
as Heino Keiji on the other side, with a stronger affirmation
to sub
cultural ethics attract an audience, not less loyal, but distinctively
more isolated: to be part of the fan audience is not only a matter
of
commitment but also a question of being initiated or not: a phenomena
probably most clearly observable in the career of Les Rallizes
des Nudes,
a Japanese band which appears only once in a year in public, with
flyers
promoting their gig which resemble pamphlets announcing a secret
conspiracy. In 1994 they played in front of an audience and in
the same
concert hall as George Clinton with Bootsy Collins did a few months
earlier.
Looking at the work of Technocrat in a broader context,
and
taking his audience into account one cannot deny the presence
of slightly
cultic elements. You involve the audience in your projects at
times. In
" Coming out, HIV" you needed 200 people to contribute
their blood, in
order to realize this project. Would it have been possible without
a cult
following?
NA: Well, first of all I cannot agree with you that I have a cult following. When I started with theatre in the early eighties, people kept on coming again and our theatre group became popular. Not that I was that immensely famous, but when I decided to turn towards art, I had accquired already a certain recognition.
People often describe you as charismatik. After all you are the leader of Technocrat. Do you have authority?
NA: Technocrat is an art group, but it doesn't have a stable core of members or organized structure. Members change with each project and the people who join are specialists in their fields e.g. sound engineers, computer programmers, medicians,etc. They contribute their specific knowledge.
Which role does religion play in your work?
NA: I see religion as having two different aspects. First there is the awe-inspiring absolutism of worship. Then there is also a finer system of beliefs and thoughts which we each apply to our daily lives. We can selectively take things from this system that we feel will lead us closer to redemption. In this way religion, in a sense, becomes a set of facts and information to be benefitted from. And at that point, I don't think it even has to be called religion anymore. Science, for instance, is the same thing. Take for example, the concept of the food chain. One animal is devoured by another, and death essentially becomes the source of nourishment and life for the predator. Buddhism speaks of the same thing through reincarnation. And if you consider DNA and hereditary genes, you can see a similiar precept. We are born from our parents genes and will pass them on through our children in an eternal chain. When Aum first came out, they appeared to merge religion and science. People couldn't understand this connection. For me it was interesting and comprehensive. But it quickly became apparant that it was not science, but rather "science fiction" based solely on mysticism and prophecy .
The idea of deconstructing social patterns and obsolete conventions in society e.g. getttig rid of the familiy structure, is central to Aum as well as central to Technocrat's work.
NA: Taking the concept of family, and simply destroying it is
futile.
What we focus on is a process of sorting out the positive and
negative
sides. Things that are supposed to have tradition are actually
not that
old. Traditional Japanese notions mostly derive from the time
after the
Meiji Restauration; they are merely 100 years old and highly artificial.
You have to analyze it.
[ Translation by Kim Marohn ] [ Images: Technocrat ] [ Thanks to Shikata Yukiko and Matthew Rosin ]
[ part of this interview has been published by SPEX ]
SAWARAGI Noi and Krystian Woznicki are part of Ulrike Gabriel's VIEWS project
SAWARAGI Noi was born in Chichibu, Saitama Prefecture in 1962. After receiving a B.A. in Philosofhy from Doshisha University in 1986, he was on the editorial staff of Bijutsu Techo until 1990. His publications include Simyureshonizumu(Simulationis, 1991) and Shihon-shugi notakitsubo(Waterfall Basin of Capitalism, 1993).
Krystian Woznicki was born in Glatz/Poland. Formed ZUCK SHOW, an agency for visual and audio arts, with Klaas Glenewinkel in Hannover, 1991. Established a ZUCK SHOW office in Tokyo, 1992.
Projects (selected): 1992 >Tokyo Scene< a TV Special with Nest, Demi Semi Quaver, Shojono Tomo and others in collaboration with TTParty [Fukushima Teruhiko, Akita Takaaki] @Et Cetera, SDR Germany , 1992 >Tokyo Underground< a Japanese Filmseries with works by: Kurosawa Jun, Kato Itaru, Kuroiwa Toshiya and others in collaboration with TTParty @ Cinevideo 5, Tollhaus/Karlsruhe , 1993 >Tokyo Angel Hospital< a Multimedia Performance with works by: Kurosawa Jun, Fukui Mikari in collaboration with Willem Velthoven, TTParty @ Roxy, Amsterdam , 1993 >Tokyo Underground< a Japanese Filmtour with works by: Fukui Shojin, Kurosawa Jun in collaboration with: Ian Kerkhov, Inka Guertler, Jacinta Hin, TTParty @ 13 cinemas in W/NEurope , 1995 >Some Japanese Films of the 90's< a library @Superball Homepage
http://www.eccosys.co.jp/VN/SB/Film
